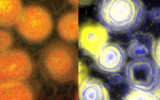

16 декабря
-
14:04
Ученые выяснили, как опасный вирус вызывает редкую форму рака
 Наука
Наука
-
13:10
Неандертальцы жгли костры и вырубали деревья: это изменило экосистемы 125 000 лет назад
 Наука
Наука
-
10:55
Генная терапия вернула слух мышам: дальше лечение протестируют на людях
 Наука
Наука
-
10:22
Perseverance выяснил, из чего состоят скалы кратера Езеро на Марсе
 Наука
Наука
-
9:19
Криозаморозка тела: псевдонаука или путь к бессмертию
 Кейсы
Кейсы
15 декабря
-
21:11
Под поверхностью Марса нашли ледник размером с Голландию
 Наука
Наука
-
16:58
Новая вакцина уничтожает клетки, которые вызывают старение организма
 Наука
Наука
-
12:54
Новый робот ползает по стенам и выполняет опасную работу за строителей
 Новости
Новости
-
12:01
Новый портативный МРТ-аппарат стоит в десятки раз дешевле обычного
 Наука
Наука
-
10:50
Дирижабль на водородном топливе будет нести груз в 150 000 кг на высоте 3 000 м
 Новости
Новости
-
10:06
НАСА показало, как зонд Parker впервые «коснулся» Солнца
 Наука
Наука
14 декабря
-
19:24
SpaceX начнет добывать ракетное топливо прямо из воздуха
 Наука
Наука
-
16:55
Посмотрите на древо всей жизни на Земле: ученые соединили 2,2 млн видов в одном проекте
 Наука
Наука
-
15:48
Хищные бактерии имитируют картину Ван Гога, когда охотятся на сородичей
Наука
Наука
-
15:18
Экзоскелет «работает» за все тело: с ним можно переносить грузы до 30 кг
 Новости
Новости
-
10:12
Важнейшая часть ледника «Судного дня» рухнет за 5 лет: это изменит всю Антарктиду
 Наука
Наука
13 декабря
-
20:06
Новая медная поверхность уничтожает бактерии всего за две минуты
 Наука
Наука
-
18:56
Посмотрите на рыбу с прозрачным лбом: ее мозг и глаза видно сквозь голову
 Наука
Наука
-
18:18
Плутон снова может стать планетой: как это произойдет и почему так важно
 Кейсы
Кейсы
-
11:19
Зонд Mars Express «пообщался» с китайским ровером на Красной планете
 Наука
Наука